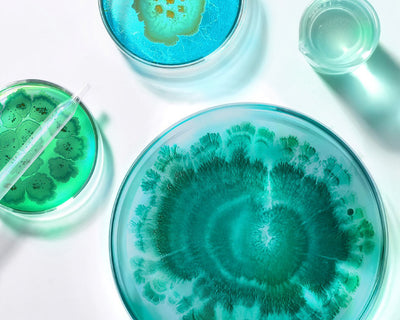
Postbiotics

- Description
- Why choose this?
- All ingredients
- Additional information
Meet Chemist At Play Oil Control Face Moisturizer, powered by Innovist, designed to control oil & sebum, provide lightweight, non-greasy hydration with a matte finish, and reduce clogged pores with...
Read MoreMeet Chemist At Play Oil Control Face Moisturizer, powered by Innovist, designed to control oil & sebum, provide lightweight, non-greasy hydration with a matte finish, and reduce clogged pores with its non-comedogenic formula.
This gel-based moisturizer for oily skin delivers fast-absorbing, shine-free hydration while helping keep pores clear and skin balanced throughout the day. Formulated in labs and dermatologically tested, it is the best moisturizer for oily skin and combination skin that struggles with excessive oil, congestion, and dehydrated yet greasy skin.
With a clinically backed 5% complex of Niacinamide, Postbiotics, and Vitamin B5, this niacinamide moisturizer for oily skin helps regulate sebum production, strengthen the skin barrier, soothe redness, and maintain clear, smooth pores with consistent use.
Why you'll love it?
✔ 92% users experienced reduced oiliness and a matte finish without dryness*
✔ 97% users agreed it absorbed quickly and felt non-greasy*
Who Is It For?
✔ If you want the best face moisturizer for oily skin that balances oil while hydrating
✔ Anyone needing a face cream for oily skin that prevents shine throughout the day
✔ If your skin is oily yet dehydrated and needs lightweight moisture
✔ If clogged pores and congestion are a concern
✔ If you want a moisturizer with niacinamide that visibly refines skin texture
✔ Anyone who wants a vitamin B5 moisturizer that strengthens the barrier without greasiness
✔ Those needing a non-comedogenic oil control moisturizer suitable for everyday use
What Makes It Work?
💧Niacinamide (Vitamin B3)- helps control excess oil, supports a stronger skin barrier, and improves uneven tone over time.
🧪Postbiotics- help balance the skin’s microbiome, strengthen the defense layer, and soothe visible redness while keeping pores clearer.
💊Vitamin B5 (Panthenol)- provides lightweight hydration, supports barrier repair, and keeps skin calm, soft, and healthy-looking.
Chemist At Play Oil Control Face Moisturizer, powered by Innovist, offers clinically backed oil control with hydration that never feels greasy. With its gel-cream texture, non-comedogenic formula, and matte finish, it is the best moisturizer for combination skin and the perfect oil-free moisturizer for oily skin that keeps pores clear and shine under control every day.
Disclaimer: Claims based on consumer trials.
Read Less- Excess oil & sebum
- All-day shine control
- Clogged pores & congestion
- Dehydrated yet oily skin
- Uneven texture & post-blemish marks
- Oily & combination skin
- Midday shine control
- Matte finish without dryness

- Controls excess oil
- Improves uneven tone
- Reduce redness
- Balance the skin microbiome

- Provides hydration
- Calms irritation

- Prevent dryness
- Strengthen skin barrier



Apply to damp skin after cleansing

Use dollop amount for your face & neck

Massage gently in circular motions, focusing on dry areas

- Controls oil while keeping skin comfortably hydrated
- Gives deep pore cleansing to help prevent future breakouts
- Strengthens the skin barrier and maintains natural pH balance

- May control oil but leave the skin dry and irritated
- May not offer deep pore cleansing, limiting acne prevention
- May not support the barrier and may disrupt the skin’s natural pH





































